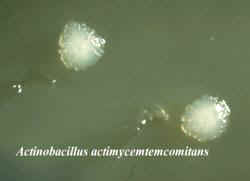

|
Salud
Dental
|
|
Microbiología de la Periodontitis |
||
| La asociación repetidamente mostrada entre la colonización subgingival bacteriana y la presencia de inflamación gingival y patología periodontal, han generado la investigación durante los últimos 20 años, para encontrar a las bacterias responsables de la perdida de inserción dental y clasificar las enfermedades periodontales por las condiciones para el desarrollo de destrucción y pérdida del ligamento. | ||
| La enfermedad periodontal se desarrolla en sitios suceptibles, con la presencia de patógenos y la ausencia de bacterias beneficiosas y con los factores medioambientales conducentes. Los factores de importancia en el huésped son la capacidad funcional de los fagocitos y del sistema inmunológico así como la capacidad regeneradora del epitelio y de bacterias subgingivales, en la superficie de la raíz , en el exudado de la bolsa y en el epitelio de la bolsa. Adicionalmente los microbios también pueden residir entre las células de este epitelio y en la parte más lateral del tejido conjuntivo por lo menos de vez en cuando. | ||
| Las oportunidades de tomar una muestra representativa de las bacterias de importancia para los procesos destructivos son mínimas. En particular como allí hay alrededor de 300 especies diferentes y algunas de ellos en las formas de clones diferentes. Es obvio que la tarea de identificar mecanismos específicos o su etiología bacteriana, es una tarea muy difícil. | ||
La lista de patógenos
periodontales sospechosos
es bastante extensa, pero
algunas bacterias están asociadas particularmente con el desarrollo de
enfermedad periodontal progresiva. Tales como:
|
||
|
||
|
||
|
Professor and Chairman,Centre for Oral Health Sciences,
Lund University, 214 21 Malmo, Sweden.
WWW Home page of Faculty of Odontology
Traducción: Marcelo A. Iruretagoyena (Odontólogo) Licenciada Adriana Verón.